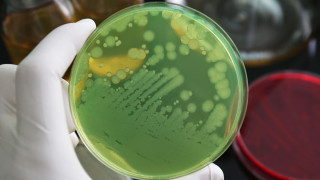
Един от сериозните проблеми пред човечеството за който не се

... си – както защитата, така и атаките. Откритието ще доведе до изключително много промени в разглеждането на механизма на болестите и методите за лечението им.
Език Бактериите - Новини
Един от сериозните проблеми пред човечеството за който не се
...... здравна организация има списък с бактериални видове, за които е от жизненоважно значение да бъдат открити нови антибиотици. Pseudomonas aeruginosa е сред първите в списъка.